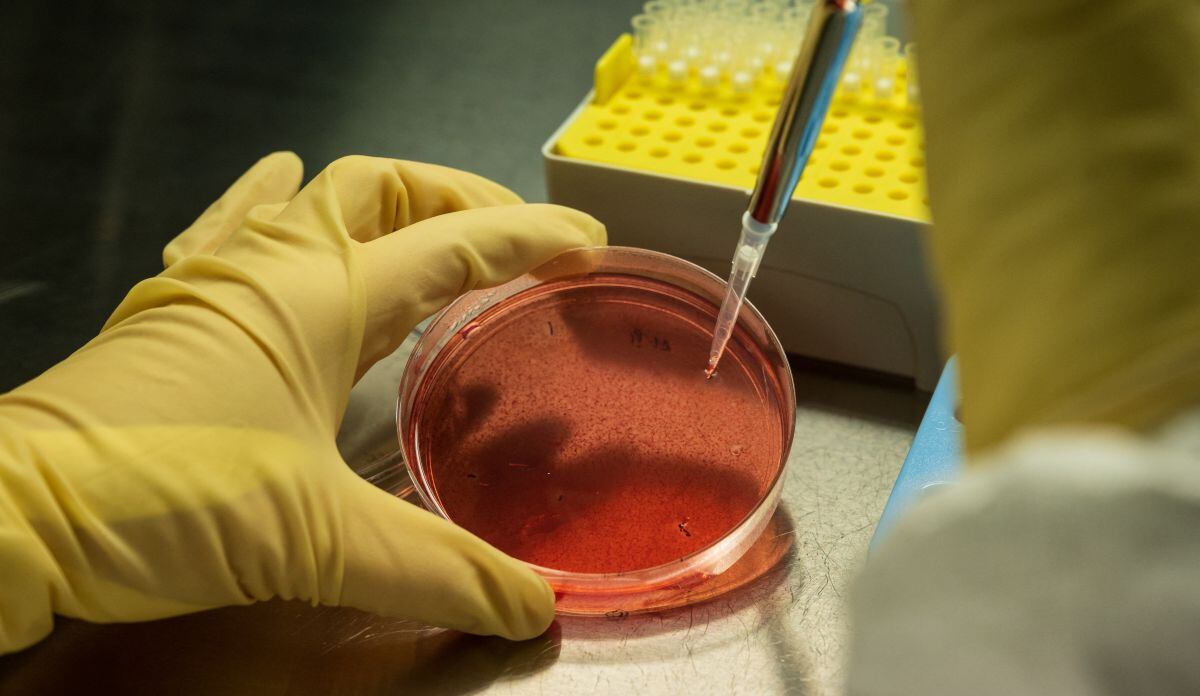
Estados Unidos viene investigando acerca del virus Merburg (Foto: referencial: AFP)

Un nuevo virus preocupa al mundo. Gran alarma en varios países viene ocasionando el brote de la enfermedad conocida como Marburgo o Marburg y que fue detectada en África Occidental de Guinea Ecuatorial, según informaron los distintos medios internacionales. Si bien el virus apareció en el continente africano existe mucho temor de que pueda expandirse hacia otros territorios tal como ocurrió con el COVID-19. Conoce aquí todo lo relacionado a esta enfermedad.
Desde que se conoció de la existencia del virus Marburg varios países han encendido las alarmas y han mostrado su preocupación por esta enfermedad y por lo que podría ocasionar en las personas de producirse un posible contagio masivo.
Es por ello que diversos medios internacionales han brindado información respecto a este virus que podría ser un peligro para el mundo. Pero no solo ellos, pues la Organización de la Salud (OMS) dio mayores alcances de esta enfermedad.
¿QUÉ ES EL VIRUS MARBURG?
De acuerdo a la Organización Mundial de la Salud, la enfermedad por el virus Marburg (EVM) fue detectada por primera vez en 1967 cuando hubo brotes en Marburgo y Frankfurt (Alemania), además de Belgrado (Serbia).
La referida entidad informó que el virus del Ébola y Marburg son distintos, pero los dos pertenecen a la familia de Filoviridae teniendo como consecuencia enfermedades con características similares.
Añade que el virus Marburg tiene una letalidad de hasta 88%, aunque si se recibe atención temprana esto podría tener una variación.

¿ACTUALMENTE HAY PERSONAS CONTAGIADAS?
CNN en español indicó que en África Occidental, epicentro del brote de la enfermedad, se reportaron en febrero:
- 9 contagiados.
- 7 fallecidos.
- 20 sospechas de contagiados.
¿CÓMO SE TRANSMITE EL VIRUS MARBURG?
La OMS dio mayores detalles del caso. En ese sentido, indica que el virus se contrae por estancia prolongada en minas o cuevas donde habitan murciélagos Rousettus.
Esto puede contagiarse a través de las personas por contacto directo con la piel que está lesionada o con herida. También se contagia por la sangre, secreciones, órganos o líquidos corporales de las personas infectadas. Pero eso no es todo, pues existe el contagio por tocar superficies y materiales que están contaminados con líquidos o secreciones del infectado.
Otras formas de contagio son:
- Inyecciones contaminadas.
- Pinchazos con agujas.
- En funerales donde las personas tienen contacto con el cuerpo del difunto infectado.
¿CUÁL ES EL TIEMPO DE INCUBACIÓN DEL VIRUS?
De acuerdo a la entidad de salud el virus Marburg puede aparecer entre el 2 y 21 días después de que la persona se haya contagiado.

¿CUÁLES SON LOS SÍNTOMAS?
- Fiebre alta.
- Cefalea intensa.
- Malestar corporal.
- Cólicos abdominales.
- Nauseas.
- Diarrea.
- Hemorragias.
- Sangrado por nariz, encías.
- Confusión.
- Irritabilidad.
¿EXISTE UN TRATAMIENTO CONTRA LA ENFERMEDAD?
La OMS también agrega que por ahora no se han autorizado tratamientos ni vacunas para combatir este virus; sin embargo, precisa que existe una terapia de apoyo mediante rehidratación oral o de manera intravenosa que puede ayudar.
Asimismo, dijo que el tratamiento de determinados síntomas podrían ayudar mucho a la persona contagiada con el virus Marburg. A la vez, recordó que la Agencia Europea de Medicamentos autorizó, en el 2020, que se puedan comercializar vacunas Zabdeno (Ad26.ZEBOV) y Mvabea (MVA-BN-Filo) contra este virus.
¿QUÉ HA HECHO ESTADOS UNIDOS ANTE ESTA SITUACIÓN?
De acuerdo a La Opinion, las autoridades de salud de Estados Unidos, a través de los Centros para el Control y la Prevención de Enfermedades (CDC), han decidido enviar a personal especializado a África para ayudar a contrarrestar los contagios por este virus.